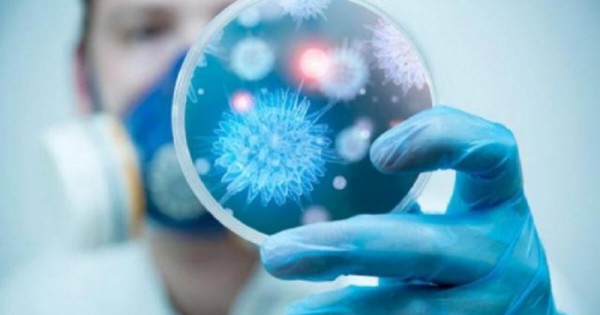

بۇعان دەيىن 14 تامىزدا 304 351 ادامنىڭ جۇقتىرعانى ەڭ جوعارعى سان بولىپ كەلگەن-ءدى, ەندى ودان دا ارتىق كورسەتكىش تىركەلىپتى.
پاندەميا قۇرساۋىنداعى مەملەكەتتەر ءتىزىمىنىڭ باسىندا بۇرىنعىداي اقش ( 6,2 ملن), ەكىنشى ورىندا برازيليا (4,1 ملن), ال ۇشتىكتە (4 ملن) ادام جۇقتىرۋىمەن ءۇندىستان بەلگىلەنسە, تورتىنشىدە (1 ملن) اداممەن رەسەي تۇر.
اقش كۆي-دەن ءولىم سانى جونىنەن دە (188 مىڭ)ادامىن جوعالتىپ ەڭ الدىندا, ودان كەيىن برازيليا (125 مىڭ), ۇشىنشىدە (69 تىس) ازاماتىنان ايرىلعان ء ۇندىستان. جەر شارىندا SARS-CoV-2-تان اجال قۇشقاندار 876 مىڭ ادامنان اسىپ كەتكەنى ايتىلعان حاباردا.





































